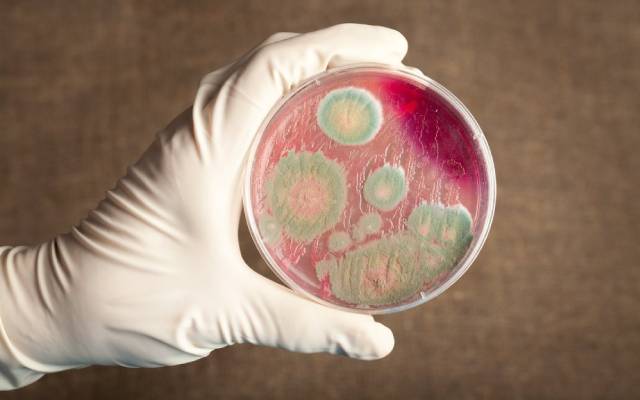

Многим известно о том, что коты и кошки могут быть в качестве переносчиков опасных для людей заболеваний. Но стоит отметить, что происхождение обратных случаев также не исключается, в результате которых уже пушистик может заразиться от человека. При контакте человека и кошки всегда существует высокий риск для последующего инфекционного распространения.
Болезни, являющиеся общими для человека и кошки
Зооантропонозы представляют собой группу инвазивных и инфекционных заболеваний, представляющих опасность, как для людей, так и для представителей животного мира.
Среди таких заболеваний отмечаются:
- Сибирская язва, представляющая собой острое инфекционное заболевание, распространяющееся, как среди диких, так и среди сельскохозяйственных животных и даже людей. Возникновение сибирской язвы происходит посредством распространения спорообразующих бактерий Bacillus anthracis. Течение заболевания проходит в кожной или септической формах. Животным свойственно сталкиваться с появлением у них кишечной или лёгочной формы сибирской язвы.
- Бруцеллёз - зоонозное инфекционное заболевание, процесс передачи которого осуществляется от уже болеющих животных к людям. Провокатором инфекции являются бактерии рода Brucella. Среди характерных признаков инфицирования называются: поражение нервной, сердечно сосудистой, половой и прочих организменных систем. Также отмечается наличие поражений опорно-двигательного аппарата. Среди клинических проявлений у болеющих бруцеллёзом отмечается наличие озноба, лихорадка.
- Бешенство - это зоонозное вирусное заболевание, возникновение которого спровоцировано поражением центральной нервной системы. Возбудителем бешенства является представитель порядка Mononegavirales семейства Rhabdoviridae. В большинстве случаев люди могут заразиться бешенством от уже болеющих им кошек, собак и различных хищных животных.
- Сап представляет собой зоонознозное заболевание, вызванное бактерией Burkholderia mallei. К людям сап может передаваться от непарнокопытных животных таких, как верблюды, лошади и ослы. Характерными признаками возникновения сапа являются: кожные, мышечные и суставные поражения; поражения слизистых оболочек и внутренних органов. Течение сапа проходит в острой и хронической формах.
- Птичий грипп - это вирусное инфекционное заболевание домашних и диких птиц, обладающее способностью для передачи от пернатых к людям. Среди характерных признаков птичьего гриппа называются следующие: общее угнетение; кровоизлияния; отёчность; кожное, мозговое, а также поражение внутренних органов. В качестве возбудителя вируса птичьего гриппа служит вирус типа А.
Достижение понимания о том, что кошка болеет
Отмечающиеся у кошки поведенческие изменения могут послужить в качестве первого признака, сигнализирующего о кошачьей болезни. В таких ситуациях хозяевам пушистиков стоит обратить внимание на следующее:
- ухудшение состояния кожного и шерстяного покровов животного, образование на покровах животного покраснений и залысин;
- о кошачьей болезни может проинформировать наличие у пушистика кашля, чихания, а также глазные и носовые выделения;
- нарушения мочеиспускания также могут сказать о том, что с организмом вашего пушистого питомца не всё в порядке.
- у болеющей кошки может отмечаться наличие плохого аппетита, или полный отказ от еды;
- в качестве признаков нездоровья пушистика могут послужить наличие у него диареи и рвоты;
- весовые изменения также могут быть в качестве признаков кошачьего нездоровья;
- о том, что с организмом вашей кошки не всё в порядке могут сообщить произошедшие у животного изменения опорно-двигательного аппарата.
В случае обнаружения у животного тех или иных признаков нездоровья со своим домашним питомцем незамедлительно следует побывать в кабинете у ветеринарного врача. Стоить не забывать своевременно прививать свою домашнюю любимицу.

Могут ли кошки заражаться от людей?
Да, заражение кошек от людей действительно возможно. Данное явление носит название - обратный зооноз. Но стоит отметить, что встречается обратный зооноз достаточно нечасто. Чаще всего отмечается о происхождении обратных случаев.
Люди могут заразить кошек следующими заболеваниями:
грипп; золотистый стафилококк; сальмонеллёз; свинка; стригущий лишай; туберкулёз.
Курящие люди также могут нанести серьёзный вред состоянию здоровья своих питомцев. Гораздо больше для животных, чем для людей, опасно пассивное курение. Табачный дым для кошек служит в качестве угрозы возникновения у пушистиков онкологических и респираторных заболеваний.
